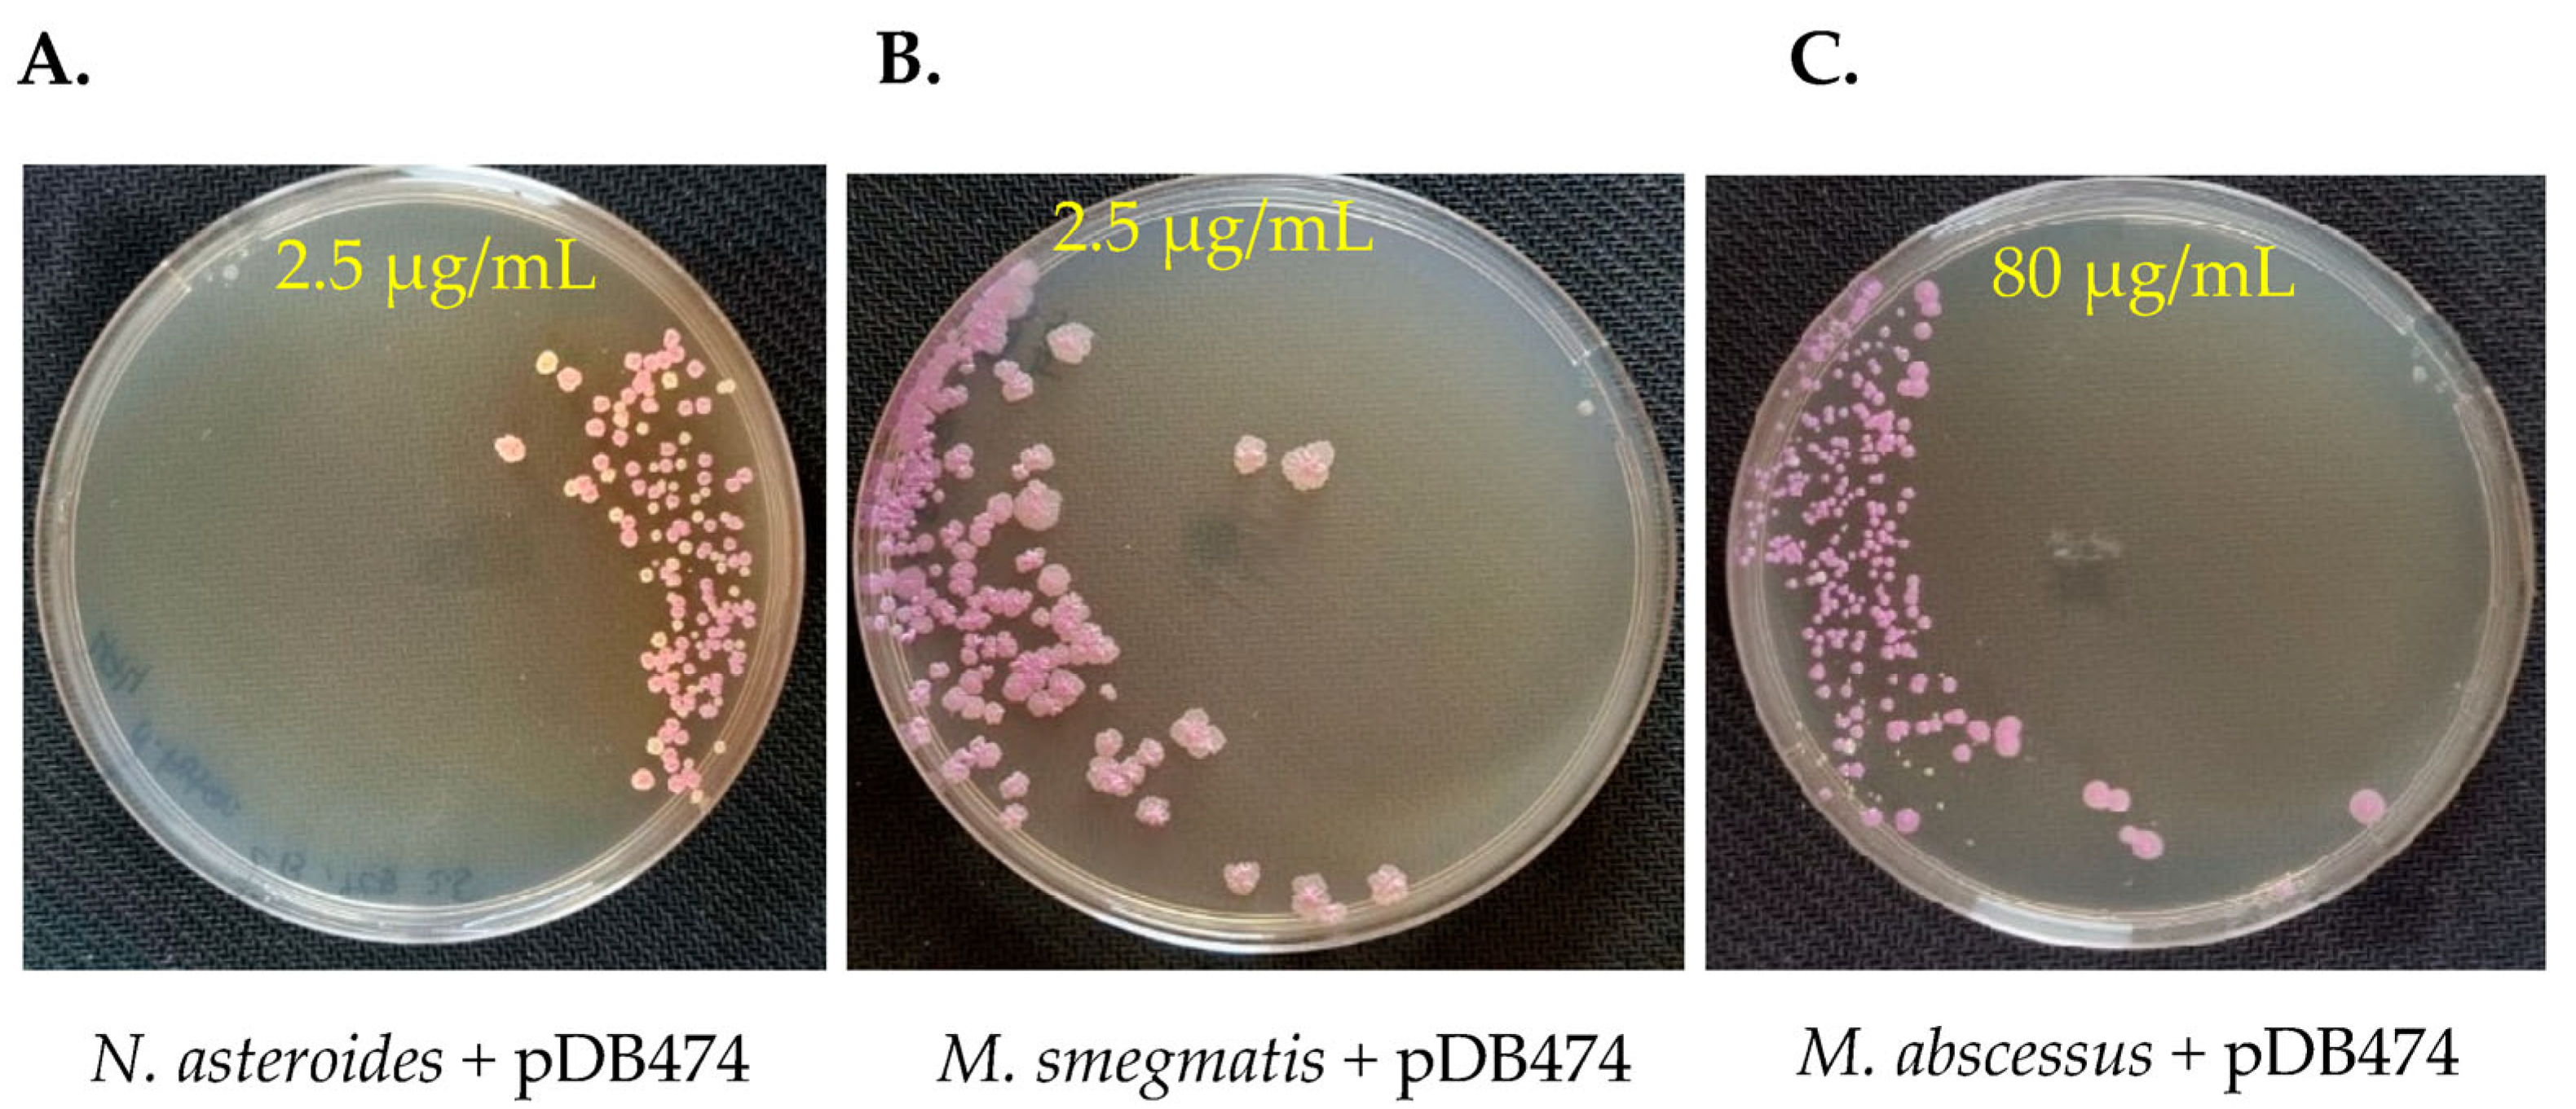
Microorganisms 11 01697 g003 Microorganisms 11 01697 g003

The Nocardial aph(2″) Gene Confers Tobramycin and Gentamicin Resistance and Is an Effective Positive Selection Marker in Mycobacteria and Nocardia
Abstract
1. Introduction
2. Materials and Methods
2.1. Bacterial Strains and Plasmids
2.2. Cloning and Expression of the aph(2″) Gene
2.3. Antimicrobial Agents and MIC Determinations
2.4. Positive Selection Efficiency Experiments
3. Results
3.1. The aph(2″) Gene Confers Resistance to Tobramycin and Gentamicin in Nocardia and Mycobacteria
3.2. The aph(2″) Gene Enables Effective Positive Selection for Plasmid Insertion in Nocardia and Mycobacteria
4. Discussion
Author Contributions
Funding
Data Availability Statement
Conflicts of Interest
References
- Heinemann, M.; Panke, S. Synthetic biology—Putting engineering into biology. Bioinformatics 2006, 22, 2790–2799. [Google Scholar] [CrossRef]
- Barka, E.A.; Vatsa, P.; Sanchez, L.; Gaveau-Vaillant, N.; Jacquard, C.; Klenk, H.-P.; Clément, C.; Ouhdouch, Y.; van Wezel, G.P. Taxonomy, Physiology, and Natural Products of Actinobacteria. Microbiol. Mol. Biol. Rev. 2015, 80, 1–43, Erratum in Microbiol. Mol. Biol. Rev. 2016, 80, iii. [Google Scholar] [CrossRef] [PubMed]
- Chakaya, J.; Khan, M.; Ntoumi, F.; Aklillu, E.; Fatima, R.; Mwaba, P.; Kapata, N.; Mfinanga, S.; Hasnain, S.E.; Katoto, P.D.M.C.; et al. Global Tuberculosis Report 2020—Reflections on the Global TB burden, treatment and prevention efforts. Int. J. Infect. Dis. 2021, 113, S7–S12. [Google Scholar] [CrossRef]
- Lee, M.-R.; Sheng, W.-H.; Hung, C.-C.; Yu, C.-J.; Lee, L.-N.; Hsueh, P.-R. Mycobacterium abscessus Complex Infections in Humans. Emerg. Infect. Dis. 2015, 21, 1638–1646. [Google Scholar] [CrossRef] [PubMed]
- Chiba, K.; Hoshino, Y.; Ishino, K.; Kogure, T.; Mikami, Y.; Uehara, Y.; Ishikawa, J. Construction of a pair of practical Nocardia—Escherichia coli shuttle vectors. Jpn. J. Infect. Dis. 2007, 60, 45–47. [Google Scholar] [PubMed]
- Ishikawa, J.; Yamashita, A.; Mikami, Y.; Hoshino, Y.; Kurita, H.; Hotta, K.; Shiba, T.; Hattori, M. The complete genomic sequence of Nocardia farcinica IFM 10152. Proc. Natl. Acad. Sci. USA 2004, 101, 14925–14930. [Google Scholar] [CrossRef] [PubMed]
- Stoffels, K.; Traore, H.; Vanderbist, F.; Fauville-Dufaux, M. The effect of combined tobramycin-clarithromycin on Mycobacterium tuberculosis isolates. Int. J. Tuberc. Lung Dis. 2009, 13, 1041–1044. [Google Scholar] [PubMed]
- Brown-Elliott, B.A.; Nash, K.A.; Wallace, R.J., Jr. Antimicrobial susceptibility testing, drug resistance mechanisms, and therapy of infections with nontuberculous mycobacteria. Clin. Microbiol. Rev. 2012, 25, 545–582. [Google Scholar] [CrossRef] [PubMed]
- Maurer, F.P.; Bruderer, V.L.; Castelberg, C.; Ritter, C.; Scherbakov, D.; Bloemberg, G.V.; Böttger, E.C. Aminoglycoside-modifying enzymes determine the innate susceptibility to aminoglycoside antibiotics in rapidly growing mycobacteria. J. Antimicrob. Chemother. 2015, 70, 1412–1419. [Google Scholar] [CrossRef] [PubMed]
- Ramón-García, S.; Otal, I.; Martín, C.; Gómez-Lus, R.; Aínsa, J.A. Novel streptomycin resistance gene from Mycobacterium fortuitum. Antimicrob. Agents Chemother. 2006, 50, 3920–3922. [Google Scholar] [CrossRef] [PubMed]
- Yazawa, K.; Mikami, Y.; Maeda, A.; Kudo, T.; Suzuki, K.-I.; Saito, N.; Kubo, A. Inactivation of kanamycin A by phosphorylation in pathogenic Nocardia. Microbiol. Immunol. 1991, 35, 39–48. [Google Scholar] [CrossRef] [PubMed]

| Strain/Plasmid/(Mutant Name) | MICs (μg/mL) |
|---|---|
| N. farcinica NCTC 11,134 | 16 |
| N. asteroides ATCC 19,247 (wt) | 0.25 |
| N. asteroides ATCC 19,247 + pMSG383 (empty vector control) | 0.25 |
| N. asteroides ATCC 19,247/+ pDB464 [pMSG383 + aph(2″)] | 16 |
Disclaimer/Publisher’s Note: The statements, opinions and data contained in all publications are solely those of the individual author(s) and contributor(s) and not of MDPI and/or the editor(s). MDPI and/or the editor(s) disclaim responsibility for any injury to people or property resulting from any ideas, methods, instructions or products referred to in the content. |
© 2023 by the authors. Licensee MDPI, Basel, Switzerland. This article is an open access article distributed under the terms and conditions of the Creative Commons Attribution (CC BY) license (https://creativecommons.org/licenses/by/4.0/).
Share and Cite
Hershko, Y.; Adler, A.; Barkan, D. The Nocardial aph(2″) Gene Confers Tobramycin and Gentamicin Resistance and Is an Effective Positive Selection Marker in Mycobacteria and Nocardia. Microorganisms 2023, 11, 1697. https://doi.org/10.3390/microorganisms11071697
Hershko Y, Adler A, Barkan D. The Nocardial aph(2″) Gene Confers Tobramycin and Gentamicin Resistance and Is an Effective Positive Selection Marker in Mycobacteria and Nocardia. Microorganisms. 2023; 11(7):1697. https://doi.org/10.3390/microorganisms11071697
Chicago/Turabian StyleHershko, Yizhak, Amos Adler, and Daniel Barkan. 2023. "The Nocardial aph(2″) Gene Confers Tobramycin and Gentamicin Resistance and Is an Effective Positive Selection Marker in Mycobacteria and Nocardia" Microorganisms 11, no. 7: 1697. https://doi.org/10.3390/microorganisms11071697
APA StyleHershko, Y., Adler, A., & Barkan, D. (2023). The Nocardial aph(2″) Gene Confers Tobramycin and Gentamicin Resistance and Is an Effective Positive Selection Marker in Mycobacteria and Nocardia. Microorganisms, 11(7), 1697. https://doi.org/10.3390/microorganisms11071697





